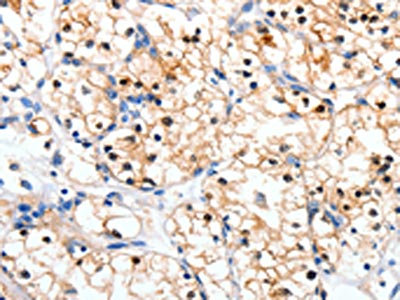

RALB Antibody
-
中文名稱:RALB兔多克隆抗體
-
貨號:CSB-PA219431
-
規格:¥1100
-
圖片:
-
The image on the left is immunohistochemistry of paraffin-embedded Human brain tissue using CSB-PA219431(RALB Antibody) at dilution 1/10, on the right is treated with synthetic peptide. (Original magnification: ×200)
-
The image on the left is immunohistochemistry of paraffin-embedded Human renal cancer tissue using CSB-PA219431(RALB Antibody) at dilution 1/10, on the right is treated with synthetic peptide. (Original magnification: ×200)
-
Gel: 10%SDS-PAGE, Lysate: 30 μg, Lane: Mouse lung tissue, Primary antibody: CSB-PA219431(RALB Antibody) at dilution 1/300, Secondary antibody: Goat anti rabbit IgG at 1/8000 dilution, Exposure time: 30 seconds
-
-
其他:
產品詳情
-
Uniprot No.:
-
基因名:
-
別名:5730472O18Rik antibody; dRalb antibody; GTP binding protein antibody; Ralb antibody; RALB_HUMAN antibody; RAS like protein B antibody; RAS like proto oncogene B antibody; Ras related GTP binding protein B antibody; Ras-related protein Ral-B antibody; v ral simian leukemia viral oncogene homolog B (ras related GTP binding protein) antibody; v ral simian leukemia viral oncogene homolog B (ras related) antibody; V ral simian leukemia viral oncogene homolog B antibody
-
宿主:Rabbit
-
反應種屬:Human,Mouse,Rat
-
免疫原:Synthetic peptide of Human RALB
-
免疫原種屬:Homo sapiens (Human)
-
標記方式:Non-conjugated
-
抗體亞型:IgG
-
純化方式:Antigen affinity purification
-
濃度:It differs from different batches. Please contact us to confirm it.
-
保存緩沖液:-20°C, pH7.4 PBS, 0.05% NaN3, 40% Glycerol
-
產品提供形式:Liquid
-
應用范圍:ELISA,WB,IHC
-
推薦稀釋比:
Application Recommended Dilution ELISA 1:500-1:5000 WB 1:500-1:2000 IHC 1:10-1:50 -
Protocols:
-
儲存條件:Upon receipt, store at -20°C or -80°C. Avoid repeated freeze.
-
貨期:Basically, we can dispatch the products out in 1-3 working days after receiving your orders. Delivery time maybe differs from different purchasing way or location, please kindly consult your local distributors for specific delivery time.
-
用途:For Research Use Only. Not for use in diagnostic or therapeutic procedures.
相關產品
靶點詳情
-
功能:Multifunctional GTPase involved in a variety of cellular processes including gene expression, cell migration, cell proliferation, oncogenic transformation and membrane trafficking. Accomplishes its multiple functions by interacting with distinct downstream effectors. Acts as a GTP sensor for GTP-dependent exocytosis of dense core vesicles. Required both to stabilize the assembly of the exocyst complex and to localize functional exocyst complexes to the leading edge of migrating cells. Required for suppression of apoptosis. In late stages of cytokinesis, upon completion of the bridge formation between dividing cells, mediates exocyst recruitment to the midbody to drive abscission. Involved in ligand-dependent receptor mediated endocytosis of the EGF and insulin receptors.
-
基因功能參考文獻:
- our work provides new insight into the specific roles of Ras effector pathways in acute myeloid leukemia and has identified RALB signaling as a key survival pathway PMID: 27556501
- High RALB expression is associated with acute myeloid leukemia. PMID: 27991934
- Inhibition of Ral GTPases Using a Stapled Peptide Approach. PMID: 27334922
- These findings suggest that RalB might be one of the targets for facilitating the invasive phenotype of malignant gliomas induced by GGTase-I. PMID: 25573158
- High RALB mRNA expression is associated with non-small-cell lung cancer growth and progression. PMID: 24389431
- Integrin alpha(v)beta expression and the resulting KRAS-RalB-NF-kappaB pathway were both necessary and sufficient for tumour initiation, anchorage independence, self-renewal and erlotinib resistance. PMID: 24747441
- nutrient starvation induces RALB deubiquitylation by accumulation and relocalization of the deubiquitylase USP33 to RALB-positive vesicles PMID: 24056301
- a novel RalB-mediated biochemical and signaling mechanism for invadopodium formation PMID: 22331470
- Study finds that the Ras-like small G protein, RalB, is localized to nascent autophagosomes and is activated on nutrient deprivation. PMID: 21241894
- Non-phosphorylated RalB is associated with bladder cancer cell growth and metastasis. PMID: 20940393
- RALA and RALB collaborate to maintain tumorigenicity through regulation of both proliferation and survival; RALB is specifically required for survival of tumour cells but not normal cells PMID: 12856001
- These observations define the mechanistic contribution of RalGTPases to cancer cell survival and reveal the RalB/Sec5 effector complex as a component of TBK1-dependent innate immune signaling. PMID: 17018283
- RalB was found to mediate SDF-1-induced migration PMID: 18227351
- Backbone dynamics and the structure of free RalB bound to the GTP analogue GMPPNP were determined using NMR spectroscopy. PMID: 19166349
- 1H, 13C and 15N resonance assignments for the small G protein RalB in its active conformation. Backbone amide dynamics parameters for a majority of residues have also been obtained PMID: 19636851
顯示更多
收起更多
-
亞細胞定位:Cell membrane; Lipid-anchor; Cytoplasmic side. Midbody.
-
蛋白家族:Small GTPase superfamily, Ras family
-
數據庫鏈接:
Most popular with customers
-
-
YWHAB Recombinant Monoclonal Antibody
Applications: ELISA, WB, IHC, IF, FC
Species Reactivity: Human, Mouse, Rat
-
Phospho-YAP1 (S127) Recombinant Monoclonal Antibody
Applications: ELISA, WB, IHC
Species Reactivity: Human
-
-
-
-
-